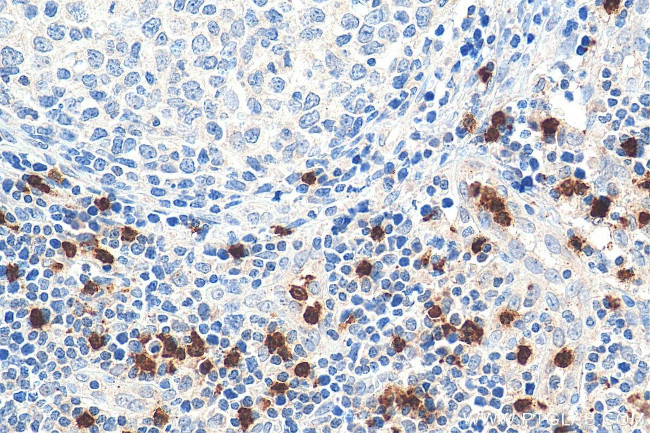
ELA2 Antibody in Immunohistochemistry (Paraffin) (IHC (P))

Search
Proteintech
ELA2 Polyclonal Antibody
{{$productOrderCtrl.translations['antibody.pdp.commerceCard.promotion.promotions']}}
{{$productOrderCtrl.translations['antibody.pdp.commerceCard.promotion.viewpromo']}}
{{$productOrderCtrl.translations['antibody.pdp.commerceCard.promotion.promocode']}}: {{promo.promoCode}} {{promo.promoTitle}} {{promo.promoDescription}}. {{$productOrderCtrl.translations['antibody.pdp.commerceCard.promotion.learnmore']}}
产品信息
27642-1-AP150UL
种属反应
宿主/亚型
分类
类型
偶联物
形式
浓度
规格
纯化类型
保存液
内含物
保存条件
运输条件
靶标信息
The neutrophil form of elastase is 218 amino acids long, with two asparagine-linked carbohydrate chains (see glycosylation). It is present in azurophil granules in the neutrophil cytoplasm. There appear to be two forms of neutrophil elastase, termed IIa and IIb.
仅用于科研。不用于诊断过程。未经明确授权不得转售。
篇参考文献 (0)
生物信息学
蛋白别名: Bone marrow serine protease; ELA2A; Elastase; elastase 2, neutrophil; Elastase-2; elastase/medullasin precursor (EC 3.4.21.37); Elastase2; granulocyte-derived elastase; HLE; Human leukocyte elastase; leukocyte elastase; Medullasin; Neutrophil elastase; neutrophil elastase precursor; neutrophil elastase precursor (EC 3.4.21.37); PE-1; PMN elastase; polymorphonuclear elastase; polymorphonuclear leukocyte elastase; unnamed protein product
基因别名: ELA2; ELANE; GE; HLE; HNE; NE; PMN-E; SCN1
UniProt ID: (Human) P08246
Entrez Gene ID: (Human) 1991